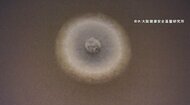

「経営責任は重大」。
小林製薬の会長と社長が、「紅麹」サプリによる健康被害が相次いだことを受けてそろって辞任することが決まった。
■死亡との関連調べる必要がある事例は97例
小林製薬の紅麹サプリをめぐっては、当初摂取した5人が死亡したと発表されるも、その後、死亡との因果関係を調べる必要がある事例が97例あることがわかっている。

また、ことし1月に最初の健康被害が会社に報告されていたにもかかわらず、公表までおよそ2 カ月かかっていた。
小林章浩社長(3/22会見):
結果としては時間かかって申し訳ないと思うし、その点で判断が遅かったと言われれば、その通りだと感じています。
■青カビの付着 知っていた大阪工場の従業員
こうした会社側の一連の対応について、弁護士でつくる委員会が検証を行っていて、報告書が23日に公表された。

報告書によると、大阪工場で働く人は紅麹を培養するタンクのフタに青カビが付着していることを知っていたものの、品質管理を現場任せにしていて会社として実態を把握できなかったという。
■行政への報告 遅れた背景に「勝手な解釈」
また、行政への報告や製品の回収が遅れた背景として「摂取と健康被害との因果関係が明確な場合に限る」と勝手に解釈していたことを挙げている。

こうした指摘を踏まえ、取締役会は健康食品の安全性に対する意識が欠けていたなどと結論づけ、経営責任をとって小林一雅会長と小林章浩社長の辞任を23日、決めた。
ただ、小林章浩社長は『被害を生じさせた責任を最後まで果たしたい』として取締役の立場で残り補償対応に専念するということだ。
■初めて創業家以外の社長が就任
小林章浩社長は来月8日に社長を辞任し、後任には山根聡専務が就任。

小林製薬としては、初めて創業家以外が経営トップに就くことになります。
■「社内のガバナンスの立て直しに取り組んで」と武見厚労相
23日午後4時半ごろ、報道陣の取材に応じた武見厚労相は「(会社の)人事についてコメントする立場にないが、有識者委員会の指摘を真摯に受け止めて、再発防止策を早急に策定し、社内のガバナンスの立て直しに取り組んでもらいたい」と述べた。

そのうえで、武見厚労相は、厚労省が直接管理している死亡事例の調査について来月中旬には大部分を終えたいと話した。
■「創業家の影響が無くなるわけではない」と専門家
創業以来ずっと一族経営だった小林製薬。
今回初めて創業家以外がトップになったことで、様々な問題の解決は前進していくのだろうか。

大阪大学大学院の教授で経済学者の安田洋祐氏は「創業家の影響が無くなるわけではない中で、新しい風をどう入れていくか注視する必要がある」と指摘する。
大阪大学大学院 安田洋祐教授:
前進に期待したいんですけれども、退任される予定の社長は、代表権がないとはいえ、取締役に留まると、会長も会長を去るわけではなくて、一定の役職に留まるということで、創業家の影響が全く無くなるということはないと思うんです。
今回報告された報告書も、80ページ超にわたる膨大な資料なわけですけれども、どういったタイプも問題が起きていたか、その際にこういったことが社内で起きたっていうことは指摘されているんですけれども、今後どう改善するかですよね。
創業家がある程度責任を果たしつつも、次の新しい風をどうやって入れていくかっていうことを注視していく必要があると思います。

健康被害を引き起こした原因物質の特定がまだできていない状況で、新社長が先頭に立って、いち早く原因物質の特定につなげられるかどうか、手腕の見せ所と言えそうだ。
(関西テレビ「newsランナー」2024年7月23日放送)